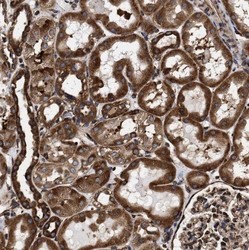

NBP1-85660
antibody from Novus Biologicals
Targeting: SERBP1
CGI-55, CHD3IP, DKFZP564M2423, HABP4L, PAI-RBP1, PAIRBP1
Antibody data
- Antibody Data
- Antigen structure
- References [2]
- Comments [0]
- Validations
- Western blot [2]
- Immunohistochemistry [7]
Submit
Validation data
Reference
Comment
Report error
- Product number
- NBP1-85660 - Provider product page

- Provider
- Novus Biologicals
- Proper citation
- Novus Cat#NBP1-85660, RRID:AB_11032773
- Product name
- Rabbit Polyclonal SERBP1 Antibody
- Antibody type
- Polyclonal
- Description
- Immunogen affinity purified. Specificity of human, mouse, rat SERBP1 antibody verified on a Protein Array containing target protein plus 383 other non-specific proteins.
- Reactivity
- Human, Mouse, Rat
- Host
- Rabbit
- Isotype
- IgG
- Vial size
- 0.1 ml
- Storage
- Store at 4C short term. Aliquot and store at -20C long term. Avoid freeze-thaw cycles.
Submitted references Immunofluorescence and fluorescent-protein tagging show high correlation for protein localization in mammalian cells.
Matrix remodeling stimulates stromal autophagy, "fueling" cancer cell mitochondrial metabolism and metastasis.
Stadler C, Rexhepaj E, Singan VR, Murphy RF, Pepperkok R, Uhlén M, Simpson JC, Lundberg E
Nature methods 2013 Apr;10(4):315-23
Nature methods 2013 Apr;10(4):315-23
Matrix remodeling stimulates stromal autophagy, "fueling" cancer cell mitochondrial metabolism and metastasis.
Castello-Cros R, Bonuccelli G, Molchansky A, Capozza F, Witkiewicz AK, Birbe RC, Howell A, Pestell RG, Whitaker-Menezes D, Sotgia F, Lisanti MP
Cell cycle (Georgetown, Tex.) 2011 Jun 15;10(12):2021-34
Cell cycle (Georgetown, Tex.) 2011 Jun 15;10(12):2021-34
No comments: Submit comment
Supportive validation
- Submitted by
- Novus Biologicals (provider)
- Main image

- Experimental details
- Western Blot: SERBP1 Antibody [NBP1-85660] - Analysis in mouse cell line NIH-3T3 and rat cell line NBT-II.
- Submitted by
- Novus Biologicals (provider)
- Main image

- Experimental details
- Western Blot: SERBP1 Antibody [NBP1-85660] - Analysis in human cell line NTERA-2.
Supportive validation
- Submitted by
- Novus Biologicals (provider)
- Main image

- Experimental details
- Immunohistochemistry-Paraffin: SERBP1 Antibody [NBP1-85660] - Staining of human cervix, uterine shows strong cytoplasmic positivity in squamous epithelial cells.
- Submitted by
- Novus Biologicals (provider)
- Main image

- Experimental details
- Immunohistochemistry-Paraffin: SERBP1 Antibody [NBP1-85660] - Staining of human endometrium shows strong cytoplasmic positivity in glandular cells.
- Submitted by
- Novus Biologicals (provider)
- Main image

- Experimental details
- Immunohistochemistry-Paraffin: SERBP1 Antibody [NBP1-85660] - Staining of human testis shows strong cytoplasmic positivity in cells in seminiferous ducts.
- Submitted by
- Novus Biologicals (provider)
- Main image

- Experimental details
- Immunohistochemistry-Paraffin: SERBP1 Antibody [NBP1-85660] - Staining of human fallopian tube shows moderate to strong cytoplasmic positivity in glandular cells.
- Submitted by
- Novus Biologicals (provider)
- Main image

- Experimental details
- Immunohistochemistry-Paraffin: SERBP1 Antibody [NBP1-85660] - Staining of human thyroid gland shows strong cytoplasmic positivity in glandular cells.
- Submitted by
- Novus Biologicals (provider)
- Main image
- Experimental details
- Immunohistochemistry-Paraffin: SERBP1 Antibody [NBP1-85660] - Staining of human kidney shows strong cytoplasmic positivity in cells in tubules.
- Submitted by
- Novus Biologicals (provider)
- Main image

- Experimental details
- Immunohistochemistry-Paraffin: SERBP1 Antibody [NBP1-85660] - Staining of human prostate shows strong cytoplasmic positivity in glandular cells.